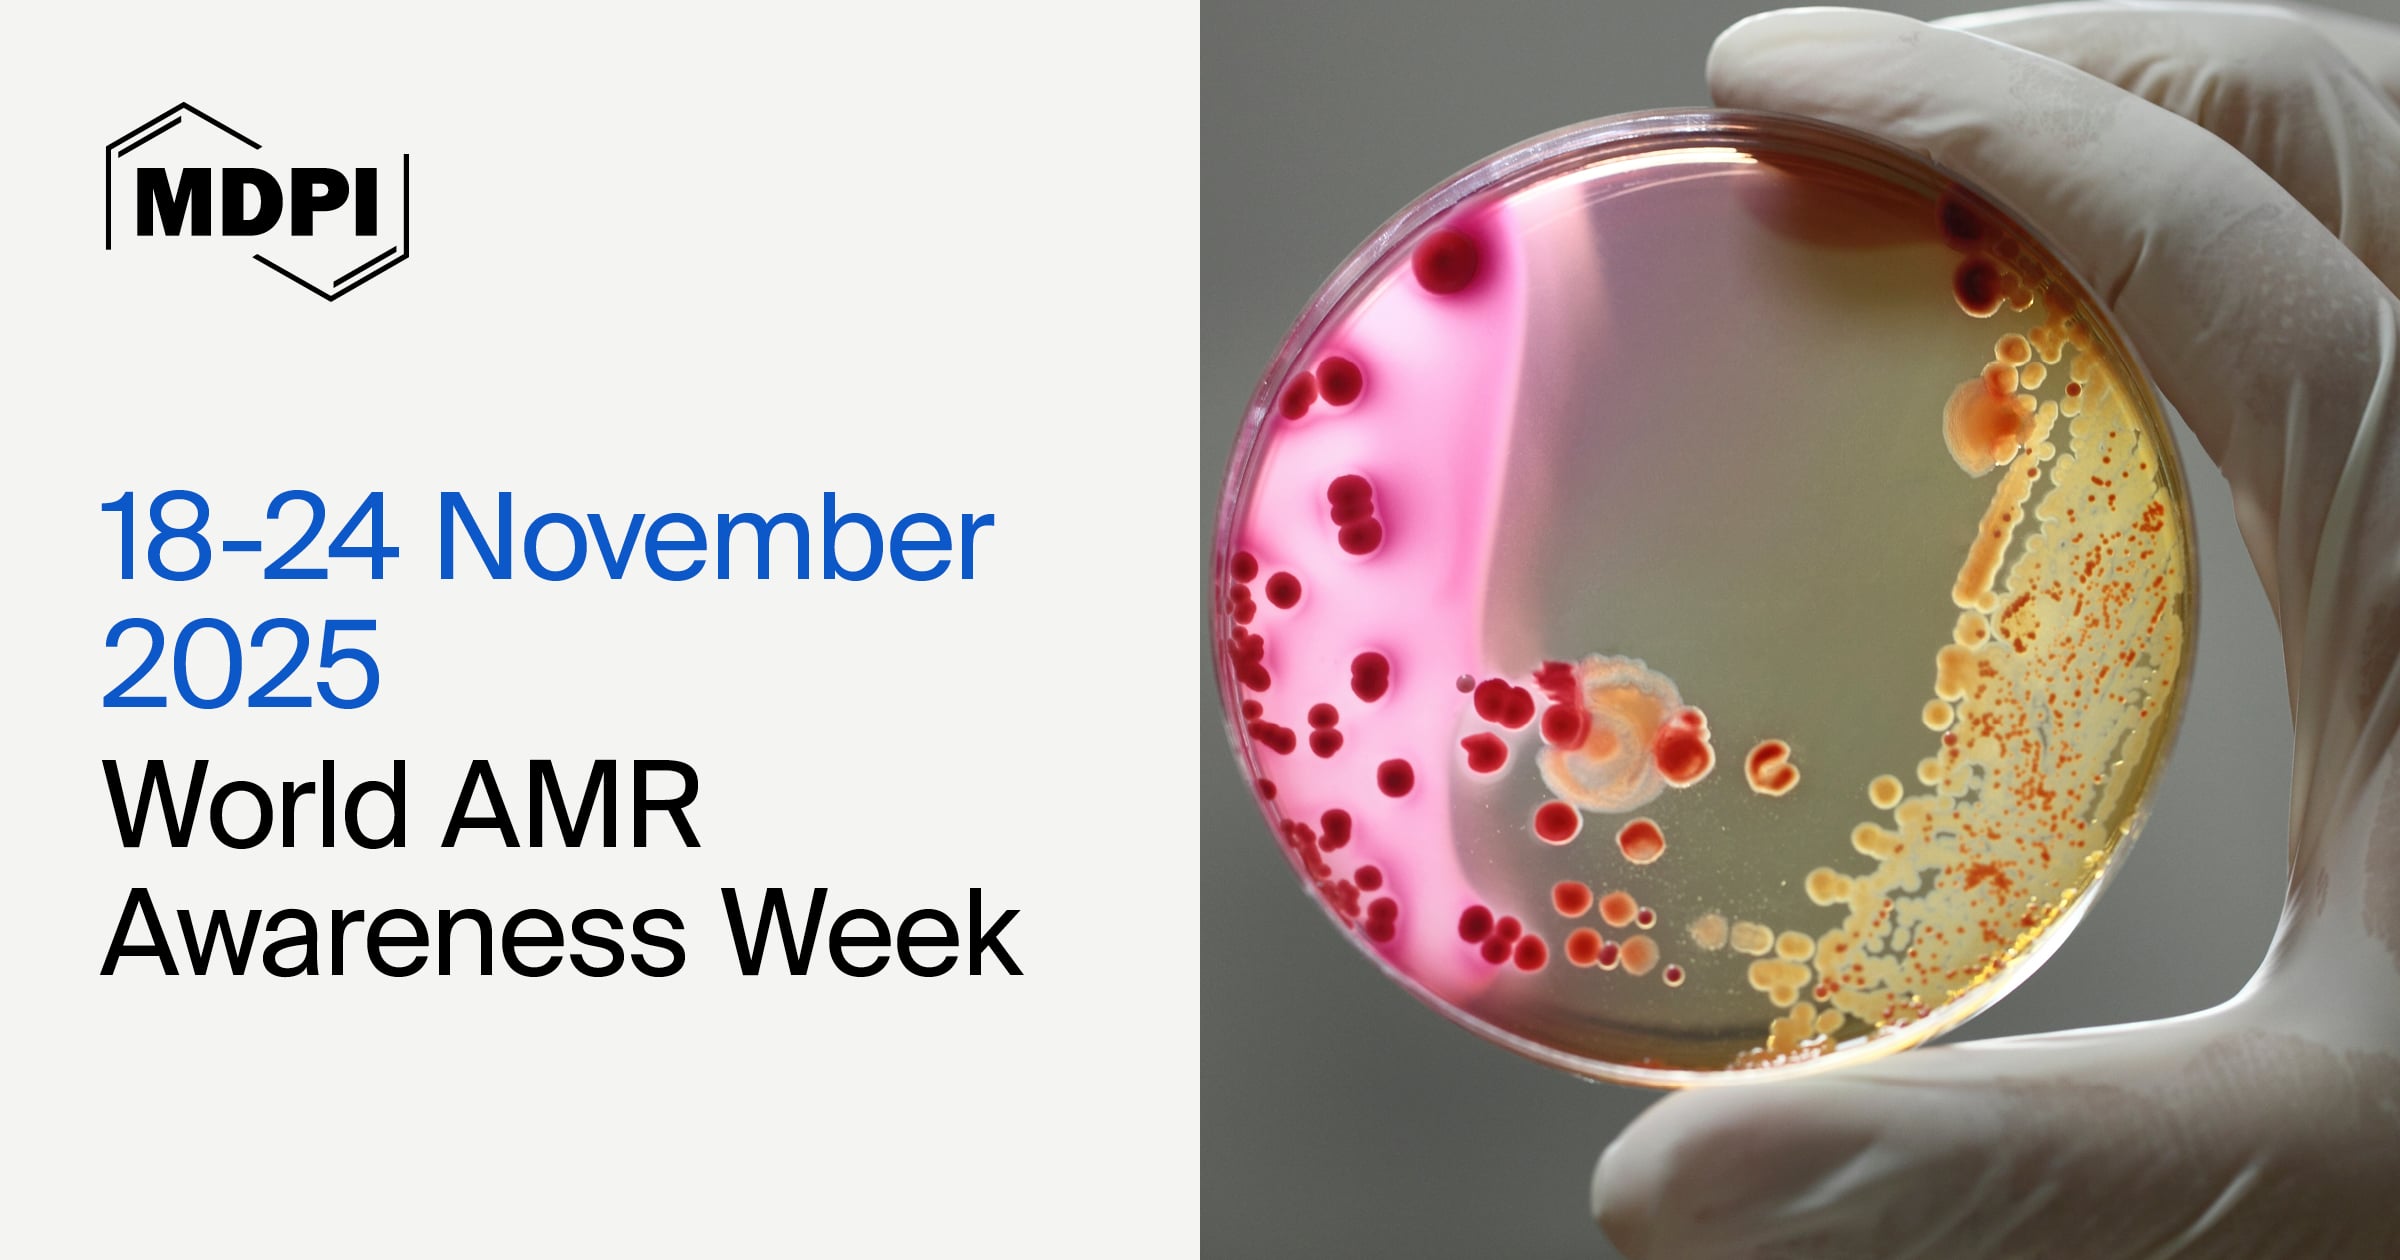
World AMR Awareness Week—“Act Now: Protect Our Present, Secure Our Future”, 18–24 November 2025

World AMR Awareness Week—“Act Now: Protect Our Present, Secure Our Future”, 18–24 November 2025
World AMR Awareness Day 2025 draws attention to the urgent global challenge of antimicrobial resistance (AMR)—one of the greatest threats to public health, food security, and sustainable development. This year’s theme, “Act Now: Protect Our Present, Secure Our Future”, calls on the international community to take immediate, coordinated, and sustained action to preserve the effectiveness of life-saving antimicrobials. AMR affects every region of the world and every aspect of modern medicine, from surgery and cancer therapy to animal health and agriculture. Without effective antibiotics, common infections and minor injuries could once again become deadly.
To address this growing crisis, selected MDPI journals provide leading platforms for advancing research on antimicrobial resistance, surveillance, stewardship, and innovative therapeutic strategies. These include studies on new antibiotics, resistance mechanisms, diagnostic tools, infection control, and global policy frameworks. Through curated articles, Special Issues, and reprints, these journals foster cross-disciplinary collaboration among researchers, clinicians, and policymakers to combat AMR through innovation, education, and evidence-based practice.
World AMR Awareness Day serves as a powerful reminder that tackling antimicrobial resistance requires shared responsibility, sustained investment in research and innovation, and collective global action to secure a healthier, more resilient future for all.

|
Biology & Life Sciences |
Medicine & Pharmacology |
|
|
|
|
Engineering |
|


|
Date and time: 21 November 2025, 9:00 a.m. CET |
||||
|
Webinar ID: 883 6849 1341 |
||||
|
Feel free to register for this webinar here! |
||||
|
|
||||
|
Invited Speakers: |
||||
|
Dr. José F. Cobo-Díaz, |
Dr. Ana Alastruey-Izquierdo, |
Dr. Anam Ahsan, |
Prof. Dr. Michaela Lackner, |
Dr. Elena Perrin, |
|
|
|
|
|
|

“Antibacterial, Antifungal, Antiviral Activity, and Mechanisms of Action of Plant Polyphenols”
by Slavena Davidova, Angel S. Galabov and Galina Satchanska
Microorganisms 2024, 12(12), 2502; https://doi.org/10.3390/microorganisms12122502
”An Overview of the Recent Advances in Antimicrobial Resistance”
by Manuela Oliveira, Wilson Antunes, Salete Mota, Áurea Madureira-Carvalho, Ricardo Jorge Dinis-Oliveira and Diana Dias da Silva
Microorganisms 2024, 12(9), 1920; https://doi.org/10.3390/microorganisms12091920
“A Mini-Review of In Vitro Data for Candida Species, Including C. auris, Isolated during Clinical Trials of Three New Antifungals: Fosmanogepix, Ibrexafungerp, and Rezafunesgin”
by Ana Espinel-Ingroff and Nathan P. Wiederhold
J. Fungi 2024, 10(5), 362; https://doi.org/10.3390/jof10050362
“ESKAPE: Navigating the Global Battlefield for Antimicrobial Resistance and Defense in Hospitals”
by Kamna Ravi and Baljit Singh
Bacteria 2024, 3(2), 76-98; https://doi.org/10.3390/bacteria3020006
Special Issues:
|
“Fungal Infections and Antifungals” |
“Unraveling Genomic Mechanisms of Stress Tolerance and Antimicrobial Resistance in Foodborne Pathogens” |

“A Six-Step Protocol for Monitoring Antimicrobial Resistance Trends Using WHONET and R: Real-World Application and R Code Integration”
by Fabio Ingravalle, Antonio Vinci, Marco Ciotti, Carla Fontana, Francesca Pica, Emanuele Sebastiani, Clara Donnoli, Martino Guido Rizzo, Dario Tedesco, Silvia D’Arezzo et al.
Methods Protoc. 2025, 8(5), 115; https://doi.org/10.3390/mps8050115
“Improved Prognostic Accuracy of NEWS2 Score with Triage Data in Adults with Bacterial Sepsis: A Retrospective Cohort Study”
by Pietro Pozzessere, Roberto Lovero, Corrado Crocetta, Najada Firza, Vincenzo Brescia, Angela Pia Cazzolla, Mario Dioguardi, Francesco Testa, Marica Colella and Luigi Santacroce
Int. J. Transl. Med. 2025, 5(4), 44; https://doi.org/10.3390/ijtm5040044
“Prevalence and Antimicrobial Resistance of Typhoid Fever in Ghana: A Systematic Review and Meta-Analysis”
by Frederick Kungu, Aaron Awere-Duodu and Eric S. Donkor
Diseases 2025, 13(4), 113; https://doi.org/10.3390/diseases13040113
“Antimicrobial Resistance Patterns and Biofilm Analysis via Sonication in Intensive Care Unit Patients at a County Emergency Hospital in Romania”
by Ioana Roxana Codru, Bogdan Ioan Vintilă, Alina Simona Bereanu, Mihai Sava, Livia Mirela Popa and Victoria Birlutiu
Pharmaceuticals 2025, 18(2), 161; https://doi.org/10.3390/ph18020161
Special Issues:
|
“Hospital-Acquired Infections: Evolving Threats and Epidemiological Insights” |
“Global Partnerships in Response to Antimicrobial Resistance: From Policy to Practice” |

“Antimicrobial and Anti-Inflammatory Potentials of Silver Tungstate Nanoparticles, Cytotoxicity and Interference on the Activity of Antimicrobial Drugs”
by Washington de Souza Leal, Juliane Zacour Marinho, Isabela Penna Ceravolo, Lucas Leão Nascimento, Antonio Otávio de Toledo Patrocínio and Marcus Vinícius Dias-Souza
Drugs Drug Candidates 2025, 4(3), 30; https://doi.org/10.3390/ddc4030030
“Release Profile and Antibacterial Activity of Thymus sibthorpii Essential Oil-Incorporated, Optimally Stabilized Type I Collagen Hydrogels”
by Caglar Ersanli, Ioannis Skoufos, Konstantina Fotou, Athina Tzora, Yves Bayon, Despoina Mari, Eleftheria Sarafi, Konstantina Nikolaou and Dimitrios I. Zeugolis
Bioengineering 2025, 12(1), 89; https://doi.org/10.3390/bioengineering12010089
“Antimicrobial Peptides from Frogs of the Glandirana Genus”
by Frederick Harris, David A. Phoenix and Sarah R. Dennison
Biologics 2024, 4(4), 444-507; https://doi.org/10.3390/biologics4040027
“Phytochemical Composition and Antimicrobial and Antibiofilm Effect of Myrciaria cauliflora Hydroethanolic Extract against Staphylococcus aureus and Acinetobacter baumannii”
by Luciane Dias de Oliveira, Ana Luisa Monteiro Ribeiro, Sthéfani de Oliveira Dias, Geovani Moreira da Cruz, Raquel Teles de Menezes, Lara Steffany de Carvalho, Mariana Gadelho Gimenez Diamantino, Thaís Cristine Pereira, Maria Cristina Marcucci and Amjad Abu Hasna
Methods Protoc. 2024, 7(4), 60; https://doi.org/10.3390/mps7040060
“LL-37: Structures, Antimicrobial Activity, and Influence on Amyloid-Related Diseases”
by Surajit Bhattacharjya, Zhizhuo Zhang and Ayyalusamy Ramamoorthy
Biomolecules 2024, 14(3), 320; https://doi.org/10.3390/biom14030320
Special Issues:
|
“Development of Antibacterial Drugs to Combat Drug-Resistant Bacteria: 2nd Edition” |
“Combating Antimicrobial Resistance Spread in Food and Drinks Using Bacteriophage Technologies” |
|
“Targeting Biofilm-Associated Infections: Mechanistic Insights, Challenges, and Therapeutic Innovations” |
“Combating Antimicrobial Resistance: Translational Science to Clinical Practice” |

“Antimicrobial Resistance Gene Patterns in Traditional Montenegrin Njeguški Cheese Revealed by qPCR”
by Vesna Milanović, Giorgia Rampanti, Andrea Cantarini, Federica Cardinali, Giuseppe Paderni, Aleksandra Martinovic, Andrea Brenciani, Lucia Aquilanti, Andrea Osimani and Cristiana Garofalo
Genes 2025, 16(9), 1089; https://doi.org/10.3390/genes16091089
“Immunotherapy Potential of Animal-Sourced Probiotic Bacteria”
by Isaac Oluseun Adejumo
Biologics 2025, 5(3), 17; https://doi.org/10.3390/biologics5030017
“Screening and Genomic Profiling of Antimicrobial Bacteria Sourced from Poultry Slaughterhouse Effluents: Bacteriocin Production and Safety Evaluation”
by Nuria Peña, Irene Lafuente, Ester Sevillano, Javier Feito, Diogo Contente, Estefanía Muñoz-Atienza, Luis M. Cintas, Pablo E. Hernández and Juan Borrero
Genes 2024, 15(12), 1564; https://doi.org/10.3390/genes15121564
“The Impact of Antibiotics and Steroids on the Nasal Microbiome in Patients with Chronic Rhinosinusitis: A Systematic Review According to PICO Criteria”
by Antonella Loperfido, Carlo Cavaliere, Elona Begvarfaj, Andrea Ciofalo, Giovanni D’Erme, Marco De Vincentiis, Antonio Greco, Stefano Millarelli, Gianluca Bellocchi and Simonetta Masieri
J. Pers. Med. 2023, 13(11), 1583; https://doi.org/10.3390/jpm13111583
Special Issues:
|
“Antimicrobial Resistance (AMR) in the Food Chain: Detection Gaps and Mitigation Strategies” |
“Microbiota in Human Disease” |


 |
Med. Sci. Forum, 2025, ECA 2025 The 4th International Electronic Conference on Antibiotics Highlights
Click here to read the full list of papers. |
















